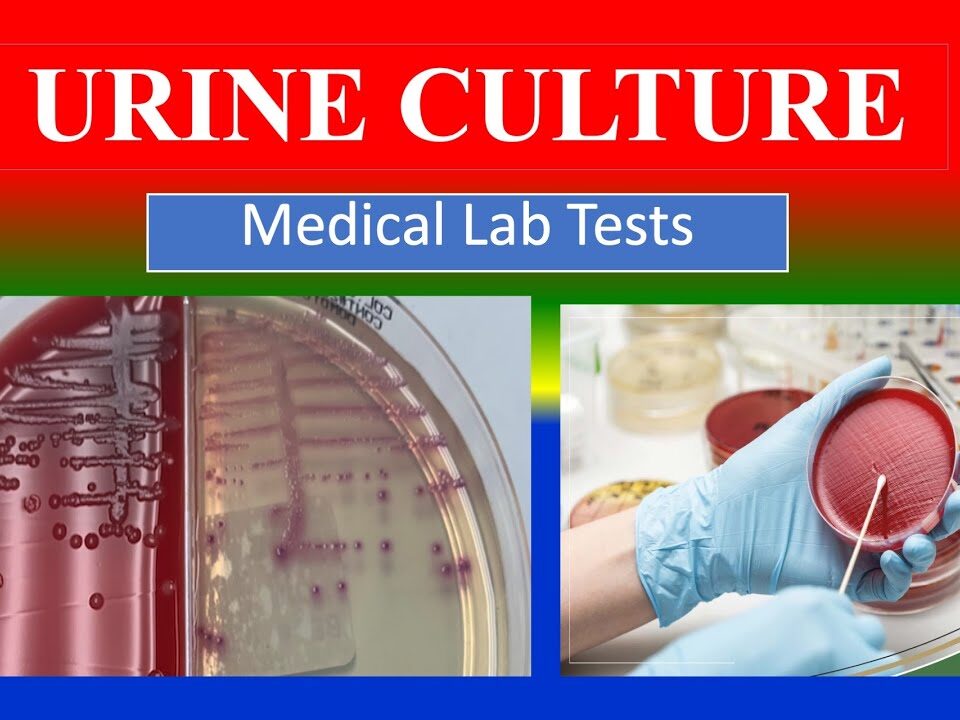

Our Blogs
January 20, 2026
Understanding Rheumatoid Arthritis Rheumatoid arthritis is a chronic autoimmune disorder that primarily affects the joints. Unlike other forms of arthritis, which are often caused by wear […]
January 13, 2026
Understanding how your body functions at its core is essential for maintaining long-term health. One of the most powerful tools for gaining insight into your body’s […]
January 8, 2026
A Female Hormone Test plays a crucial role in understanding a woman’s overall health, reproductive function, and hormonal balance. Hormones control many essential processes in the […]
January 3, 2026
Blood tests play a crucial role in modern healthcare. They help doctors understand what is happening inside the body without the need for complex procedures. From […]
December 24, 2025
Although both involve urine samples, they serve very different purposes. Understanding the difference between urine routine and urine culture is essential for patients, caregivers, and even […]
December 16, 2025
Welcoming a newborn baby into the world is a moment filled with joy, excitement, and responsibility. Along with love and care, ensuring a baby’s health from […]
December 9, 2025
Health is the real wealth, and in today’s fast-paced world, it’s easy to ignore small signs that our body gives us. Most people visit the doctor […]
December 3, 2025
Understanding Papaya and Diabetes Papaya is a tropical fruit packed with nutrients, and many people wonder is papaya good for diabetes and whether papaya for diabetic […]
November 24, 2025
Fasting blood sugar investigation is one of the most essential diagnostic tests used in modern healthcare to assess how effectively your body processes glucose. It is […]
November 14, 2025
When it comes to diagnosing infections and understanding the root cause of urinary problems, the urine culture test plays a crucial role. This diagnostic test helps […]
November 7, 2025
Hormones are the body’s chemical messengers, controlling everything from energy levels and mood to growth, metabolism, and reproduction. When these tiny messengers fall out of balance, […]
October 30, 2025
Health begins with awareness. And awareness starts with reliable diagnostics. In a rapidly growing city like Gurgaon, where every minute counts, access to a trustworthy and […]